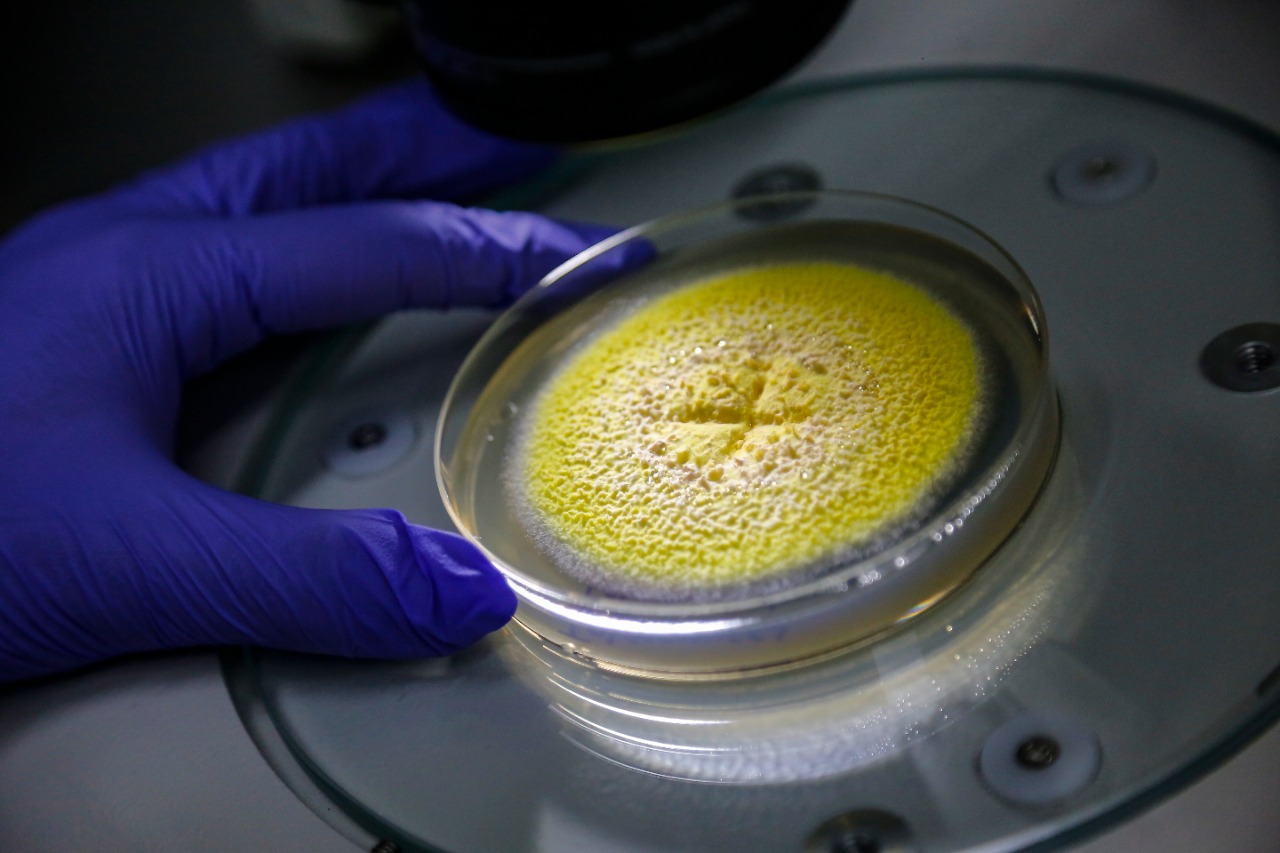

En zona rural de San Vicente de Chucurí, Santander, fue descubierto un nuevo hongo capaz de absorber el cadmio, metal pesado que causa graves problemas de salud como el cáncer en humanos.
Se trata del ‘Talaromyces santanderensis’, que fue hallado por un grupo de investigadores de la Universidad de Santander (UDES) y la Universidad EAFIT en un cultivo de cacao en una finca productora.
Este microorganismo fue hallado tras aislar hongos comunes en los suelos cacaoteros del departamento. En este proceso, los investigadores se sorprendieron al observar que uno de los hongos podía crecer en altas concentraciones de cadmio, mientras que las demás especies morían.

Al respecto, la doctora en Ciencias Biológicas, Beatriz Helena Guerra Sierra, investigadora y profesora de la UDES, afirmó que este hongo puede sobrevivir en entornos altamente contaminados por cadmio, muy por encima de los valores registrados en terrenos afectados donde se cultivan hortalizas y cereales, incluyendo cacao, arroz, tomate y lechuga.
Su ‘superpoder’
Tras observar el hongo en el microscopio y analizar sus características, se evidenció que se trataba de una rara clase de ‘Talaromyces’. Hasta ahora, solo han descrito y clasificado cinco hongos de esta especie en Colombia y este es el primero que se identificó como acumulador de cadmio, lo que lo hace aún más especial.
“Nos dimos cuenta con los estudios y marcadores moleculares que era una especie nueva para la ciencia. Representa una esperanza para seguir trabajando, nos enfocaremos en hallar los genes que el permiten acumular cadmio y vivir en lugares tan contaminados”, indicó la líder de la investigación.

Según describió Guerra Sierra, este hongo se encuentra naturalmente en los suelos, desde donde atrapa el cadmio para evitar que pase a la planta. “Es como una esponja y absorbe este elemento”, señaló.
De acuerdo con la experta, el cadmio logra contaminar las plantas de cacao llegando incluso hasta sus semillas. “Es un gran problema, porque nosotros consumimos ese fruto. Si podemos retener el cadmio en el suelo y las raíces sería fabuloso”.
Esta situación impacta negativamente la comercialización del cacao que se produce en el país, pues las exportaciones no se pueden realizar si se evidencia contaminación con metales pesados.
De esta forma, Guerra Sierra considera que este descubrimiento es una herramienta biológica promisoria para los procesos de bioremediación en los suelos agrícolas del país. “Es una alegría encontrar esta nueva especie que tiene una gran funcionalidad en el ecosistema. Queremos seguir avanzando para develar su genoma completo”.

Interés mundial
Hace unos días se reportó en el ‘Journal of fungi’ el hallazgo del ‘Talaromyces santanderensis’, que lleva este nombre en honor al departamento de Santander.
Tras la publicación en esta revista científica de alto impacto la comunidad internacional pudo conocer el hallazgo de esta especie para seguir descubriendo sus propiedades y utilidades.
El interés ha sido tal, que investigadores franceses se sintieron atraídos por el particular color amarillo limón de este hongo. “Tiene un pigmento bellísimo que podría ser usado en la industria de alimentos. Ellos están interesados en emplearlo en esta industria, así que hay un abanico de posibilidades con los hongos. Esta especie acumula cadmio, pero también puede producir otras sustancias que pueden servir para otras funciones. Incluso se podrían estudiar propiedades antibióticas o antiparasitarias”, expresó Guerra.
Problemas de salud
Beatriz Guerra afirmó que el cadmio representa graves problemas a la salud, puesto que científicamente se ha comprobado que puede causar cáncer en órganos como el hígado. “Es tan tóxico como otros metales como el arsénico, mercurio y plomo, que pueden estar inmersos en los alimentos”.
“Si una persona tiene altos niveles de cadmio, puede presentar síntomas como irritación en el estómago, diarrea, vómito y malestar. Lamentablemente, pocas veces en consulta médica al paciente le practican pruebas para medir metales pesados”, añadió.
Incluso, la investigadora advirtió que estudios desarrollados en Norteamérica precisan que este metal puede generar fragilidad en los huesos y dañar los riñones.
Llamado a las autoridades
La científica hizo un llamado para que las instituciones inviertan más en la ciencia y tecnología, pues se requiere mayor investigación para conocer el papel que cumplen los microorganismos en los ecosistemas.
“En Santander tenemos metales pesados en los suelos. Por ejemplo, el municipio de California, que es una región minera, tiene zonas contaminadas y no se le presta atención, pasa desapercibido”, comentó.
Por esta razón, la doctora en Ciencias Biológicas recomienda estudiar la biodiversidad de microrganismos que existen en el país.
Igualmente, opina que en Latinoamérica es importante hacer una vigilancia epidemiológica más rigurosa para determinar los niveles de contaminación en los alimentos y las afectaciones a la salud que generan los metales pesados, tal y como se hace en Estados Unidos y países de Europa.
Trabajo en equipo
Este hallazgo científico surgió gracias a la alianza entre la UDES y la EAFIT con el fin de desarrollar una investigación para caracterizar hongos presentes en los suelos agrícolas.
Guerra Sierra indicó en esta iniciativa trabajó de la mano del doctor Javier Correa, biólogo molecular de EAFIT. “Todo inició como un convenio de fortalecimiento interinstitucional, estamos demostrando que los pequeños proyectos también dan buenos resultados”.
El proyecto surgió en el año 2016, hasta que en 2018 se iniciaron los muestreos de suelos con el apoyo de la Federación Nacional de Cacaoteros (Fedecacao). “En la pandemia tuvimos algunos inconvenientes para poder caracterizar, pero finalmente pudimos demostrar a la ciencia que se trataba de una especie nueva”.
Más información:
Comunicaciones Externas UDES
Móvil: 318 5455587
Esta dirección de correo electrónico está siendo protegida contra los robots de spam. Necesita tener JavaScript habilitado para poder verlo.

